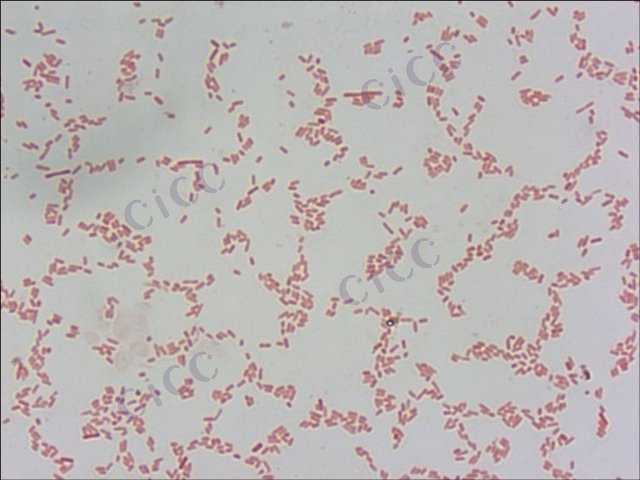
无丙二酸柠檬酸杆菌Citrobacter amalonaticusCICC 21522

无丙二酸柠檬酸杆菌Citrobacter amalonaticusCICC 21522
-
合适柠檬酸杆菌 Citrobacter koseri
BNCC369613 | 冻干粉;斜面;菌液;平板
-
布氏柠檬酸杆菌 Citrobacter braakii
BNCC388672 | 冻干粉;平板
-
弗氏柠檬酸杆菌 Citrobacter freundii CICC 10296 Citrobacter freundii
CICC 10296 | 见证书
-
弗氏柠檬酸杆菌 Citrobacter freundii CICC 10404 Citrobacter freundii
CICC 10404 | 见证书
-
弗氏柠檬酸杆菌 Citrobacter freundii CICC 25015 Citrobacter freundii
CICC 25015 | 见证书
-
弗氏柠檬酸杆菌 Citrobacter freundii derived from ATCC® 43864™
0229K | 6支/盒
-
弗氏柠檬酸杆菌DNA标准品 Citrobacter freundii DNA standard
BNCC368314 | 冻存管;(2.7±0.8)×10^5copies/mL;5管/盒

说明书下载: 菌种说明书 打管说明书
您正在浏览的产品:无丙二酸柠檬酸杆菌Citrobacter amalonaticusCICC 21522
手机版:无丙二酸柠檬酸杆菌Citrobacter amalonaticusCICC 21522
本公司销售的所有产品仅供实验科研使用,不用于人体及临床诊断。